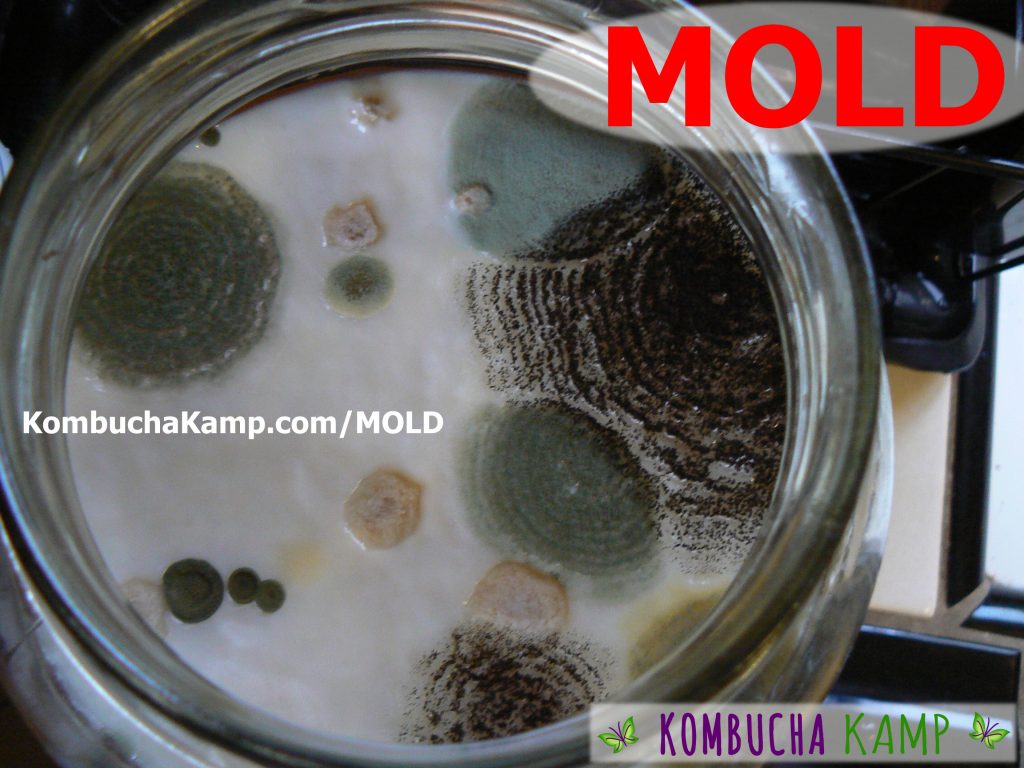

This gallery is part of the Kombucha Mold series:
- Moldy Kombucha SCOBYs and Early Mold Formations on Kombucha Brews
- Kahm Yeast on Kombucha Brew – Likely Contamination
- Healthy Kombucha SCOBY Growth including Unusual Kombucha SCOBYs
- Normal Formations on Flavored or Bottled Kombucha
- Kombucha Bubbles and Carbonation Forming In the Brew
- Normal JUN Tea Sediment at the Bottom of Brewing Jar
- Normal Kombucha Yeast Collections on Top of the Brew or Embedded in New SCOBY
- Normal Kombucha Yeast Floating in the Liquid and Under the SCOBY Surface
- Young Normal Kombucha SCOBY and Yeast Growth